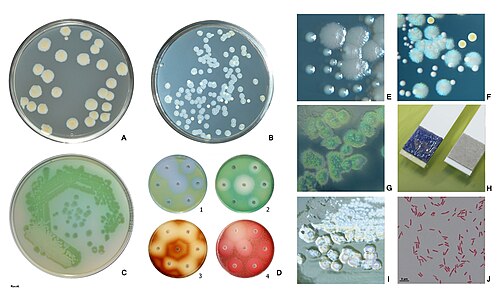

Thiomargarita magnifica
Bakterie
Thiomargarita magnifica je gramnegativní proteobakterie, která se vyskytuje v mangrovech v Karibiku, kde se jí daří na vrcholu usazenin. Živí se a roste pomocí chemosyntézy. Byla objevena v roce 2022, jakožto dosud nekultivovaná je zatím popsána jako Candidatus Thiomargarita magnifica. Jedná se o největší známou bakterii. Dorůstá velikosti až 2 cm a v optimálních… Wikipedia
Lidé také hledají
Thiomargarita magnifica – Wikipedie
Thiomargarita magnifica je gramnegativní proteobakterie, která se vyskytuje v mangrovech v Karibiku, kde se jí daří na vrcholu usazenin.
Thiomargarita magnifica - Wikipedia
Candidatus Thiomargarita magnifica is a species of sulfur-oxidizing gammaproteobacteria, found growing underwater on detached leaves of red mangroves from the Guadeloupe archipelago in the Lesser Antilles. [2 ] These filament-shaped…
Obří bakterie Thiomargarita magnifica jsou až 2 cm dlouhé…
5. 9. 2022271 zhlédnutíNa poškozených listech mangrovových porostů ve francouzském zámořském území Guadeloupe v Karibském moři žijí obří sirné bakterie Thiomargarita magnifica. Sku...
Thiomargarita namibiensis – Wikipedie
Thiomargarita namibiensis neboli Sírová perla Namibie je gramnegativní proteobakterie, která se vyskytuje na sedimentech kontinentálního šelfu.
Seznamte se s novodobým gigantem mezi bakteriemi. Na…
Hostem na Rádiu ZET byl redaktor Prima Zoom Miroslav Honsů. V rozhovoru nám popsal nového bakteriálního giganta, který vědcům značně zamotal hlavu. Je pro člověka nějak nebezpečný?
Thiomargarita namibiensis - Wikiwand
Thiomargarita namibiensis neboli Sírová perla Namibie je gramnegativní proteobakterie, která se vyskytuje na sedimentech kontinentálního šelfu. Do r. 2022 byla ...
Obrovská bakterie Thiomargarita magnifica je viditelná pouhým okem
18. 7. 2022Thiomargarita magnifica však nasadila nový rekord a všechny tyto rozměry několikanásobně předčila. Její průměrná velikost je totiž 9000 mikrometrů (0,9 cm).
Diskuse:Thiomargarita magnifica – Wikipedie
Nově popsaná Thiomargarita magnifica dorůstá velikosti až 2 cm a tím překonává i řadu mnohobuněčných organismů.“
odkazuje na služby nejen od Seznam.cz.
© 1996–2025 Seznam.cz, a.s.